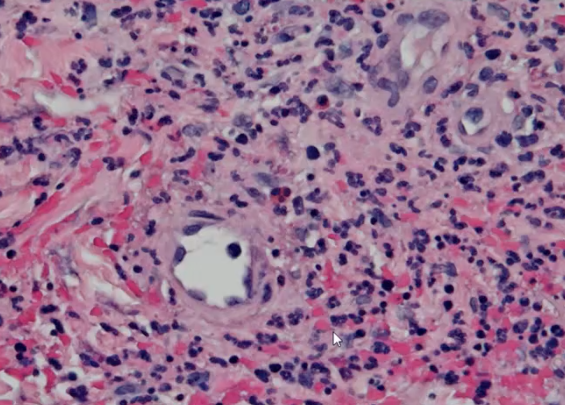

Vasculutis definition
Inflammation in the vessel walls
ANCAs and what levels of ANCAs signfiy
Antineutrophil Cytoplasmic Antibodies, one of the reasons for vasculitis. There are antibodies against the granules of the neutrophils. There are types of ANCAs:
Titers of ANCAs can be monitored to assess the effectiveness of the treatment
Describe the pathological changes and clinical features of giant cell arteritis
It is a form of T cell mediated autoimmune diseasem, type IV, caysed by TNFalpha


Giant cell arteritis, blood flow is completely obstructued and hence there is blindness since there is no blood flow to the eye

Giant cell arteritis

Fragmentation of elastic lamina associated with giant cell arteritis

Takayasu ateritis
Happens mainly in the aorta and its branches. It is associated with thickening of the vessel wall and narrowing of the lumen of the vessel.
Symptoms are high blood pressure, assymetirc blood pressure with weaker pulses in different parts of the body, there can be occular distrubrance and sight changes and there are can be cardiac symptoms

Intima is markedly markedly thick, this is Takayasu arteritis
What are these pictures showing

Tunica media is completely normal whereas the intima is markedly thick, this is takayasu arteritis

Granulomatous inflammation seen in the aorta as part of the Takayasu arteritis
Polyarteritis Nodosa
Causes fibrinoid necrosis in medium to small sized vains.

Polyarteritis nodosa

Polyarteritis Nodosa, fibrinoid necrosis

Strong evidence of fibrinoid necrosis, polyarteritis nodosa
Kawasaki disease
Acute necrotizing vasculitis of infance and early childhood with fever and rash
It is also caused by mucocutanrous lymph node syndrome
Wenger Granulomatous Disease
Affects small vessels in an aggressive way, it is classified as systemic necrotizing granlumatous vasculitis of unknown etiology.
Clinical features include: hematouria and protinurea, usually affects the lungs, similar to goodpasteur syndrome, affects the lungs by pneumonitis

Wegner disease
Churg-Strauss Syndrome
Systemic vasculitis with prominent eosinophilia that occurs in young people with asthma or allergy. There is necrotizing vasculitis in the smal and medium sized vessels, there are granulomas, eosinophilia and fibrinoid necrosis so its similar to polyarteritis nodosa. Can have a range of clinical symptoms depending on what organ is infected since this is a systemic disease
Hypersensitivity Angiitis or leukocytoclastic vasculitis or micoscopic polyangiitis
A group of inflammatory vascular lesions affecting small vessels that are thought to represent exogenous substances.
It is often drug induced or can be due to bacteria.

Purpura - palpable cutaneous hemorrhages, this is hypersensitivity angiitis

Hypersx Angiits
Hypersx Angiitis
Thromboangiitis Obliterans
Occlusive inflammatory disease of the medium and small arteries in the arms and legs
Happens most often in smokers and middle aged men
There is narrowing of the vessel wall by acute inflammation which can lead to thrombosis and infarcts. It can causes gangerenes to develop in the periphery and it is also associated with Raynaud’s phenomena

Thromboangiitis Obliteran